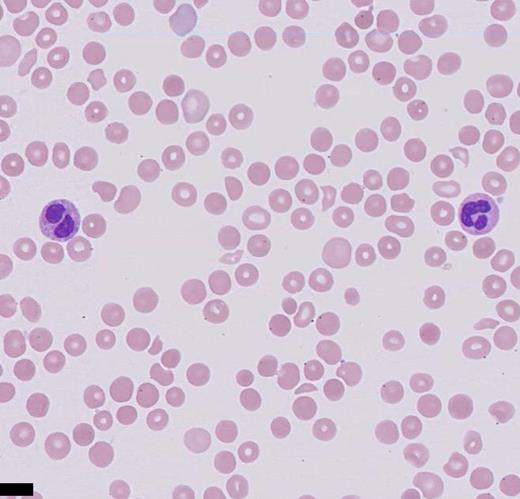
Giemsa-stained peripheral blood smear (high power).

A 62-year-old woman presented to the emergency department with abdominal pain and weakness; she has a medical history significant for end-stage renal disease secondary to focal segmental glomerulonephritis status after directed donor kidney transplantation two years ago. A computed tomography (CT) scan revealed pneumoperitoneum. She emergently underwent exploratory laparotomy with distal gastrectomy and gastrojejunostomy.
Upon admission, her platelet count was 96 × 103/µL (reference range [RR], 150-450 × 103/µL), approximately five days post-surgery her mental status waned, and platelet count decreased to 9 × 103/µL.
Other notable tests produced the following results:
| . | Value . | Reference Range . |
|---|---|---|
| Hemoglobin (g/dL) | 8.0 | 11.5-15.5 |
| Serum creatinine (mg/dL) | 3.6 | 0.5-1.4 (baseline, 3.4) |
| Lactate dehydrogenase (U/L) | 1,280 | 116-245 |
| International normalized ration | 2.3 | 0.9-1.1 |
| Mean corpuscular volume (fL) | 87 | 81-99 |
| Haptoglobin (mg/dL) | < 20 | 51-192 |
| D-dimer (µg/mL) | > 20 | < 0.40 |
| Total bilirubin (mg/dL) | 7.2 | 0.1-1.0 |
| Unconjugated bilirubin (mg/dL) | 2.7 | 0.1-1.0 |
| Conjugated bilirubin (mg/dL) | 4.5 | 0-0.3 |
| Tacrolimus level (ng/mL) | 20.8 | 5-20 |
| ADAMTS13 functional level | 24% | 69-133% |
| ADAMTS13 inhibitor | < 0.5 | < 0.5 |
| C3 complement level (mg/dL) | 78 | 83-188 |
| C4 complement level (mg/dL) | 12 | 18-45 |
| PF4 ELISA (OD) | 0.152 | < 0.4 |
| . | Value . | Reference Range . |
|---|---|---|
| Hemoglobin (g/dL) | 8.0 | 11.5-15.5 |
| Serum creatinine (mg/dL) | 3.6 | 0.5-1.4 (baseline, 3.4) |
| Lactate dehydrogenase (U/L) | 1,280 | 116-245 |
| International normalized ration | 2.3 | 0.9-1.1 |
| Mean corpuscular volume (fL) | 87 | 81-99 |
| Haptoglobin (mg/dL) | < 20 | 51-192 |
| D-dimer (µg/mL) | > 20 | < 0.40 |
| Total bilirubin (mg/dL) | 7.2 | 0.1-1.0 |
| Unconjugated bilirubin (mg/dL) | 2.7 | 0.1-1.0 |
| Conjugated bilirubin (mg/dL) | 4.5 | 0-0.3 |
| Tacrolimus level (ng/mL) | 20.8 | 5-20 |
| ADAMTS13 functional level | 24% | 69-133% |
| ADAMTS13 inhibitor | < 0.5 | < 0.5 |
| C3 complement level (mg/dL) | 78 | 83-188 |
| C4 complement level (mg/dL) | 12 | 18-45 |
| PF4 ELISA (OD) | 0.152 | < 0.4 |
Abbreviations: ADAMTS13, A disintegrin and metalloproteinase with thrombospondin-1-like domains 13; ELISA, enzyme-linked immunosorbent assay.
A. Thrombotic microangiopathy, thrombotic thrombocytopenia purpura
B. Thrombotic microangiopathy, other
C. Heparin-induced thrombocytopenia
D. Antibody-mediated renal allograft rejection
Sorry, that was not the preferred response.
Correct!
The presence of schistocytes on the peripheral blood smear, along with the laboratory findings (high lactate dehydrogenase, low haptoglobin, elevated unconjugated bilirubin, anemia, and thrombocytopenia) are consistent with a thrombotic microangiopathy (TMA) process. The differential diagnoses of TMA include heparin-induced thrombocytopenia (HIT), thrombotic thrombocytopenia purpura (TTP), hemolytic-uremic syndrome (HUS), and atypical HUS. The potential causes of TMA in this patient include acquired TMA secondary to drug toxicity (tacrolimus), atypical HUS, and infection. Stool polymerase chain reaction was negative for Shigella spp. or enterohaemorrhagic Escherichia coli. Given the patient’s supratherapeutic level of tacrolimus, a calcineurin inhibitor (CNI), the diagnosis of CNI-TMA was strongly considered, and therapeutic plasma exchange (TPE) and steroids were initiated. While atypical HUS is a possibility, it is a diagnosis of exclusion in this case. CNI-TMA is rare but is a known complication associated with supratherapeutic levels of CNIs such as tacrolimus. Injury to the endothelial cell is the nidus common to all forms of TMA. Causative agents associated with TMA include bacterial Shiga toxins, endotoxins, viruses, antibodies, immunocomplexes, and certain drugs that are toxic to endothelial cells. Reported incidence of tacrolimus-associated TMA ranges from one to 4.7 percent, occurring usually within the first year of transplantation but possibly developing at any time post-transplantation.1 Although the exact mechanism is unknown, it is likely due to deficiency of the von-Willebrand factor (vWF) –cleaving enzyme A disintegrin and metalloproteinase with thrombospondin-1–like domains 13 (ADAMTS13), which cleaves ultralarge vWF into monomers, allowing for ultralarge vWF accumulation and clotting cascade initiation.2 The largest case series of tacrolimus-associated TMA to date, showed response to TPE in 80 percent of individuals using recovery of platelet count to 150 × 103/µL and hemoglobin to eight to10 g/dL as measurable end points.3 According to the American Society for Apheresis 2016 guidelines, CNI-TMA is a category 3 indication for TPE, which implies that there might be some benefit from performing TPE as an adjunct therapy to the primary treatment plan.4
Option A is incorrect owing to a PLASMIC score of four (one point for each of the following: platelet count, international normalized ration, presence of hemolysis, and absence of active cancer) of a maximum seven. Thus, there is a very low likelihood for TTP.5 Severely reduced ADAMTS13 activity (<5%) plus or minus the presence of an inhibitor or IgG antibodies, confirms the diagnosis of TTP.6 The ADAMTS13 level in this case was low but not lower than 10 percent, and without the presence of an inhibitor.
Option C is incorrect as calculation of the 4Ts score revealed a low probability of HIT. Additionally, a PF4 enzyme-linked immunosorbent assay was normal.
Option D is also incorrect. Antibody-mediated renal allograft rejection, although a primary histologic diagnosis, would be more consistent with rising creatinine values and proteinuria without evidence of microangiopathic hemolytic anemia. Testing for donor-specific antibodies was negative.
While it is important to initiate therapy as soon as possible, it is crucial to differentiate TTP from other causes of TMA for long-term management. There can also be clinical and laboratory similarities in post-transplantation CNI-induced TMA and atypical HUS. Admittedly, atypical HUS is also a difficult diagnosis and requires a send-out panel that will take time. Also, the current picture is confounded by elements of disseminated intravascular coagulation. After no improvement seen from TPE, the patient was started on eculizumab and had a good response.7
References
References
Drs. Asif, Parker, and Aldarweesh indicated no relevant conflicts of interest.